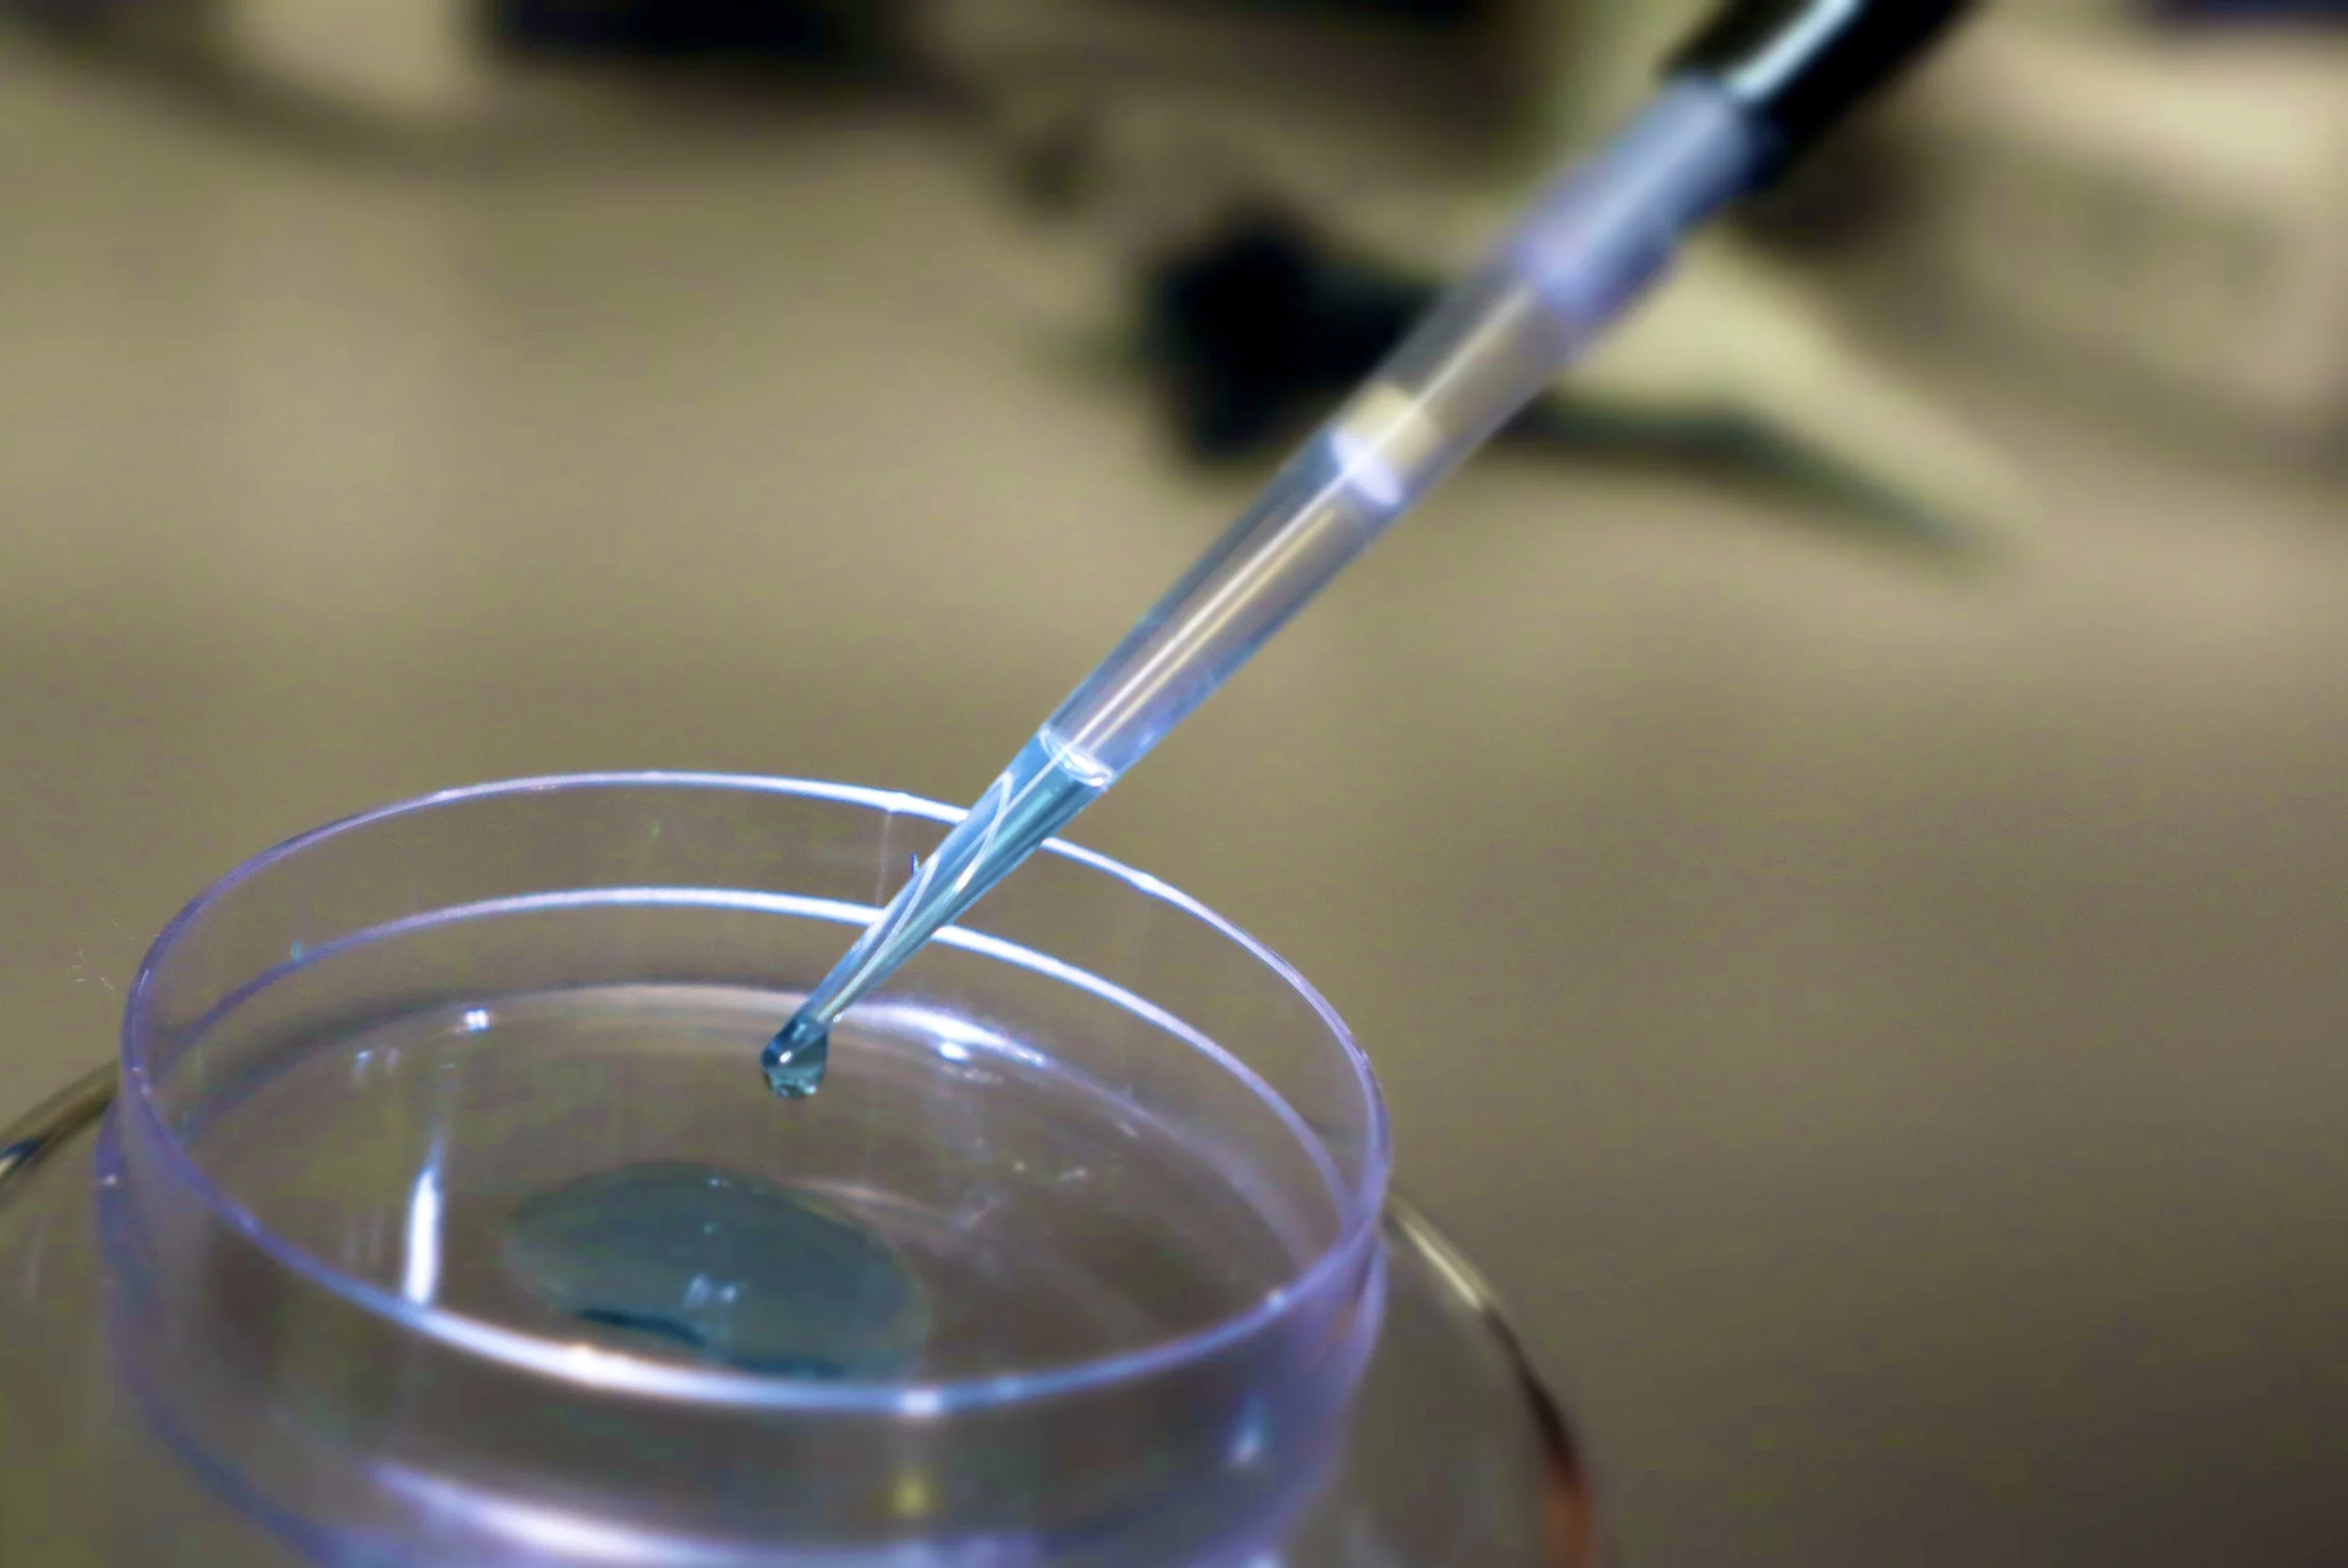

Research
Cancer - a disease of the whole body
We discover targetable mechanisms of paraneoplasia, i.e. mechanisms by which tumors and tumor associated factors and molecules impact the organism.
Patients with cancer display tumor-driven physiological, behavioral, biochemical, and immunological alterations. We study these paraneoplastic effects in preclinical models and clinical trials.
Statistical modelling of host organ function
Developing and utilizing the best approach to data collection and analysis is essential for laboratory and clinical research. Using large data sets from clinical trials and routine clinical practice, we have contributed to development of care for patients. We have developed a new model to estimate glomerular filtration rate (GFR).

